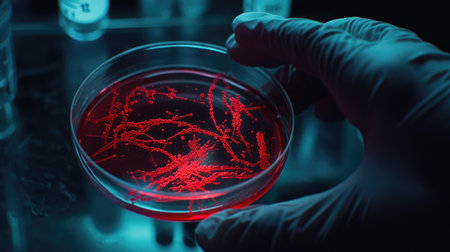
Laboratory shot of a Petri dish with active microorganism culture, showing complex structures under bright lab lighting, ideal for microbiology visuals.の素材

素材 - Laboratory shot of a Petri dish with active microorganism culture, showing complex structures under bright lab lighting, ideal for microbiology visuals.
作品情報
Laboratory shot of a Petri dish with active microorganism culture, showing complex structures under bright lab lighting, ideal for microbiology visuals.
- ID:259086443
- 作品種別:
- 作者名:suphauarrn Manosri
キーワード
- active
- analyzing
- battle
- biochemistry
- biological
- biology
- biotechnology
- cell
- cellular
- chemical
- chemist
- chemistry
- close-up
- closeup
- color image
- colourful
- contemporary
- detailed
- development
- discovery
- disease
- doctor
- dynamic
- hand
- health
- healthcare and medicine
- immune
- infection
- interaction
- laboratory
- lifestyles
- medicine
- microscopic
- modern
- organism
- people
- pipette
- process
- protection
- purple
- research
- science
- scientist
- study
- surreal
- technology
- tube
- vibrant
- virus
類似作品
Petri dishes wi...
Laboratory glas...
A futuristic sc...
Glass bottles i...
Lots of dirty d...
Meat samples in...
Biology lab cou...
A spacious labo...
Explore a moder...
A clear glass d...
Modern Laborato...
Scientist worki...
Petri dishes fi...
Scientist worki...
A person is hol...
A glass sphere ...
Team of scienti...
A microbiologis...
young scientist...
high-tech labor...
Science lab wit...
A vivid close-u...
Scientist pipet...
A modern labora...
Pharmacy and ch...
A scientist exa...
3d rendering of...
Science laborat...
Scientist worki...
Science and Lif...
Modern microsco...
High-tech labor...
Laboratory shel...
Female scientis...
A modern labora...
Scientist holdi...
Hands, plant sc...
Team Asian scie...
Scientist worki...
Siphon Coffee o...
A macro shot of...
GMO concept. Sc...
Futuristic burg...
Chemical Labora...
Close-up of a g...
Modern Lab Setu...
Pharmacy and ch...
Vibrant stacks ...
Advanced roboti...